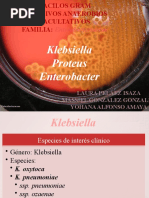
Download Bacilos Gramneg Klebs_ Ent y Prot_2011_10 by royer944 SN56179038 doc pdf

- Manual of Clinical Microbiology 10th Edition Murray by Mohsen Haleem SN:331793629
- Microbiology Culture Media Manual by David GarcÃa V. SN:28514268
- Caldo Rojo de Fenol by nash_patlan SN:56608190
- Tioglicolato by poloyensen SN:125517351
- Copia de Elaboracin de PNO s by DamianSalazar SN:46897442
- cicloheximida by Jesús Ibarra SN:54189458
- Bactriolgicos en Infecciones Intrahospitalarias by sociedad de servicios farmaceuticos a la comunidad SN:64450224
- Agar Eosina y Azul de Metileno Emb by sonyaaaa141289 SN:27834137
- Clasificacion de Las Bacterias by GinoJossue SN:18944592
- Pathogenic Organism by arnish29 SN:43166229
- Caldo Clark y Lubs by Oscar Ramirez SN:149061978
- Protocolo Esterilizacion de Biberones2 by Johana Bebita SN:102591661
- Grupo_1_violeta _Espinola_Odontologia_trabajo_segunda_unidad.pdf by Ivan Castillo Valladares SN:204117745
- Infections dues aux bact�ries ana�robies de la flore endog�ne (Clostridium difficile et Actinomyc by RIMA BATAH SN:57223958
- Antimicrobial Potentialities of Mangrove Plant Avicennia Marina by Dr. Varaprasad Bobbarala SN:17438106
- Meios_Cultura[1] by Lauravicente SN:50620983
- Bacilos Gramneg Klebs_ Ent y Prot_2011_10 by royer944 SN:56179038
- Capitulo3- FUNDAMENTOS PARA EL DX MICOLÃ"GICO by Davide Mobili Rocaro SN:159951046
- 2006 References by willygope SN:53576820
- McFarland Standards by Fitria InSi Aulani SN:68605276
- Manual Toma Muestras by guinard4521 SN:55378130
- In Vitro Antimicrobial Activity of Two Mangrove Plants by Dr. Varaprasad Bobbarala SN:17438127
- Respiration by สมชาย à¸à¸²à¸"โรจนะ SN:35338617
- Manual de Micologia by rockkko SN:17617375
- Archives of Clinical Microbiology by iMedPub SN:62828919
- A Rare Presentation of Community-acquired Pneumonia Caused by Corynebacterium pseudodiptheriticum: A Case Report. by iMedPub SN:38968820
- Manual of Clinical Microbiology 1 by Drashua Ashua SN:145213157
- Pathogenic Organism Chart by pkdo2003 SN:248579115
- Excoecaria Agallocha l. Antimicrobial Properties by Dr. Varaprasad Bobbarala SN:23867454
- Silabus Mikrobiologi Dan Parasitologi Rev 04 Sep 2013(1) by armein_rowi SN:168336543
Arsip Blog
-
▼
2019
(4713)
-
▼
March
(493)
- Lists Manual Book Rxz 5 Speed
- Ebook Presentation Of Self Goffman
- Lists Extended Essay Requirements
- Lists Presentation Remote Cheap
- Lists Pe Lesson Plan Reflection
- Collections It Ebook Hub
- Collections Duluth Public Library Ebooks
- Examples Expository Essay About Education
- Examples Manual Vs Automatic Camera
- Downloads Lange Manual Hoist-A-Top
- Ebook Learn Latin Free Online Course
- Learn Manual Reel Mower On Bermuda
- Lists Guitar Lesson Zz Top Tush
- Ebook Presentation Board Dimensions
- Examples A Lesson Before Dying Jackie Robinson
- Learn Learn Spanish In No Time
- Free Learn College Calculus
- Lesson Presentation Box For Bottles
- Learn Ebooksoda Reviews
- Learn Prezi Presentation Mac Download
- Ebook Make Online Presentation In Powerpoint
- Lists Learn To Read Hooked On Phonics
- Lists Zoo Book Quotes
- Examples Ebookers Experience
- Lesson Lesson Plan Sample Objectives
- Lesson Manual Sod Cutter Ireland
- Free Ebook Xamarin Android
- Examples Essay Examples About College
- Lists Learning A Language Research
- Learn Journal Of Communications Media Studies
- Collections The Manual Of Section Book
- Ebook Ict Lesson Plan Powerpoint
- Learn E-Journal Updates
- Ebook What Is A Journal Bearing Turbo
- Collections W204 Manual Gear Knob
- Downloads Hubspot Ebook Landing Page
- Lesson Journalism Games Online Free
- Free Learn Sql Mumbai
- Collections News Journal Delivery Jobs
- Downloads Ebook Photography Pdf
- Ebook Learn Latin Self Study
- Free Learn Python The Hard Way Threading
- Lesson Presentation On Indoor Games
- Collections Writing Prompts Killer
- Downloads Manual Omaha Carreu
- Free Lesson Plan In English Prefixes
- Ebook Une Du Journal Le Monde 12 Janvier 2015
- Examples Lesson Plan On Action Verbs
- Ebook Geo Tracker Manual Locking Hubs
- Lists 5 Speed Manual Keychain
- Lesson 944 Manual Steering Rack Conversion
- Collections Editing An Essay Worksheet
- Free Learn Coding Using Mac
- Collections Learn Oracle Fusion
- Downloads Lesson Plans On Protein Nutrition
- Learn Ebook Cover Canva
- Free Five Paragraph Essay Hamburger Model
- Lists Powerpoint Presentation Key Shortcut
- Learn Manual Stick Car Rental
- Ebook Learn Python In Mobile
- Ebook Learn How To Draw Numbers
- Downloads Murray Pr Manual Of Clinical Microbiology
- Downloads Lesson Plan On The Number 1
- Free Learn Spanish In No Time
- Collections Journal News Cars For Sale
- Lesson Electronics Repair Guide Ebook Download
- Lesson Free Ebook Pdf Game Of Thrones
- Lesson Learn Sql Mumbai
- Downloads Journal Tf1 Journal 13H
- Learn Learn English Through Gujarati Books
- Lists Learn Medical Physics
- Free Learn It Programming Languages
- Free Learn Python Programming Fabrizio Romano Pdf
- Lesson Learn Python Beginners Free
- Lesson Rent Ebooks App
- Learn Journal Gastrointestinal Oncology Impact Factor
- Learn World Journal Of Clinical Oncology Impact
- Learn Journaling For Middle School Students
- Ebook Kostenlose Ebooks Kindle Amazon
- Downloads Learn X Particles
- Lesson Oem Tools Manual Fluid Extractor
- Lists Learn French Montreal
- Ebook Wake Up Lesson Plan
- Learn Essay Of Education
- Examples Ebooks Low Cost
- Collections Learn Farsi Online Skype
- Lists Learn Python Coding Free
- Examples Learnsmart Exercises
- Free Expository Essay About Education
- Downloads Essay Guidelines For Colleges
- Downloads Learn English To French
- Collections Essay Description Of My Best Friend
- Lists Lesson Plan In Araling Panlipunan Grade 1
- Lists Learn Dutch Grammar Youtube
- Free Manual Lymphatic Drainage Lipedema
- Examples Manual Football Manager 2019
- Learn Nordictrack Elliptical Manual Pdf
- Learn Paper Kite Outline
- Free Manual Wool Press For Sale
- Examples Note Taking Journal Software
-
▼
March
(493)
Powered by Blogger.
Mengenai Saya
Tuesday, March 26, 2019
Downloads Murray Pr Manual Of Clinical Microbiology
Subscribe to:
Post Comments (Atom)
Cari Blog Ini
-
Model Adev Salariat Ordin 903 Din 2007 by Guzu Login SN:57857194 2011 YA Conf Schedule Grid ...
-
Using Facebook to move your business forward by Facebook SN:38079999 HOW TO ACTIVATE SBI MOB...
-
C# STEP BY STEP by MarcusB.Jaquez SN:317621338 How to Become a Good c# Programmer by LearnI...

No comments:
Post a Comment